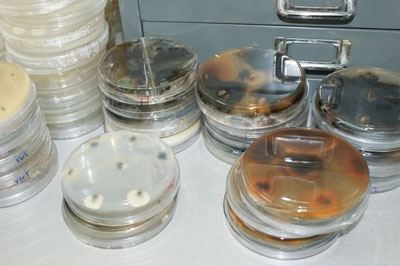
Microorganismos benéficos para la agricultura

El Seminario sobre Alternativas para incrementar el uso, producción y comercialización de microorganismos benéficos en la agricultura, organizado por el Instituto Nacional Autónomo de Investigaciones Agropecuarias (INIAP), con la participación técnica de AgResearch-Nueva Zelanda y la Escuela Superior Politécnica de Chimborazo, fue un espacio para compartir los resultados de las investigaciones en control biológico generadas por el INIAP y otras instituciones, con el fin de unir esfuerzos y avanzar en el control biológico de plagas.
A este Seminario, realizado en el Auditorio de la Facultad de Recursos Naturales de la ESPOCH, Riobamba, asistieron profesionales, productores y estudiantes interesados en el control biológico en la agricultura.
Trevor Jackson de AgResearch-Nueva Zelanda, señaló que en colaboración con el INIAP se está ejecutando un proyecto, mediante el cual se ha implementado un laboratorio que está ubicado en la Estación Experimental Santa Catalina, en el cual se está trabajando en la producción de poblaciones de microorganismos que son útiles en el campo; se ha ofrecido apoyo a las empresas pequeñas y medianas que están trabajando en este campo.
En Ecuador, señala Trevor, hay mucho entusiasmo sobre el control biológico y a esos pequeños laboratorios queremos asistirles para mejorar sus productos.
Wilson Vásquez, técnico del INIAP, señaló que el proyecto, que se está desarrollando con AgResearch-Nueva Zelanda, tiene la duración de 4 años y se está en el tercer año de ejecución. En este tiempo se ha logrado que el INIAP, a más de un laboratorio de producción de microorganismos, tenga un grupo de técnicos que están capacitados en esta área.
Otro de los adelantos de importancia en este Proyecto, señaló Wilson Vásquez, es el trabajo que se ha realizado con microorganismos bajo las condiciones que tiene el productor. Esta labor se ha realizado en dos cultivos de importancia para el país, como es la papa en la provincia de Chimborazo, y el cultivo de mora en la provincia de Tungurahua.
En papa se está investigando el control del gusano blanco utilizando Beauveria bassiana, un hongo entomopatógeno, con buenos resultados, en condiciones climatológicas de alta humedad.
En Tungurahua se está utilizando trichoderma, un hongo que habita en el suelo, para resolver el problema de muerte descendente en mora, investigación que ha dado buenos resultados.
Dyct – ECOticias.com– innovaticias.com